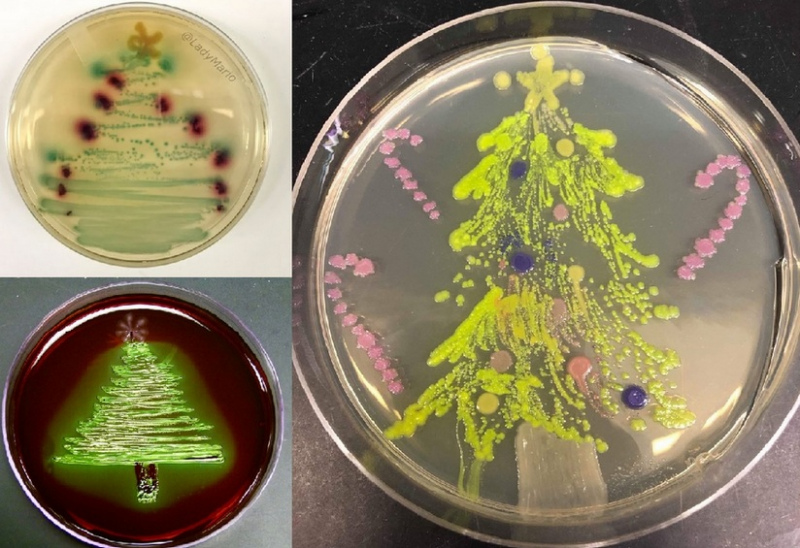

|
SILA
|
|
ความคิดเห็นที่ 60 เมื่อ 18 ธ.ค. 19, 14:28
|
|
"ตามไฟ" ตาม(ข้างบ้าน)นั้น สั้นๆ ไฟแรงเฟร่อ
TWAT referring to a person considered obnoxious or stupid. (นอกจากนี้ยังมีที่ใช้ในความหมายติดเรท 21+ ด้วย)
|
|
|
|
บันทึกการเข้า
|
|
|
|
|
SILA
|
|
ความคิดเห็นที่ 61 เมื่อ 18 ธ.ค. 19, 14:29
|
|
ต้นคริสต์มาสประดับไฟสูงใหญ่ทะลุหลังคา
|
|
|
|
บันทึกการเข้า
|
|
|
|
|
SILA
|
|
ความคิดเห็นที่ 62 เมื่อ 18 ธ.ค. 19, 14:33
|
|
"หลงไฟ"
|
|
|
|
บันทึกการเข้า
|
|
|
|
เทาชมพู
เจ้าเรือน
หนุมาน
    
ตอบ: 41829
ดูแลเรือนไทย วิชาการ.คอม
|
|
ความคิดเห็นที่ 63 เมื่อ 18 ธ.ค. 19, 16:15
|
|
นำเพลงคุณปู่คลิฟ ริชาร์ด สมัยยังหนุ่มมาต้อนรับคริสต์มาสและส่งท้ายปีเก่าค่ะ
|
|
|
|
|
บันทึกการเข้า
|
|
|
|
เทาชมพู
เจ้าเรือน
หนุมาน
    
ตอบ: 41829
ดูแลเรือนไทย วิชาการ.คอม
|
|
ความคิดเห็นที่ 64 เมื่อ 18 ธ.ค. 19, 16:17
|
|
เพลงที่มีความหมายยิ่ง สำหรับคริสตศาสนิกชน ในช่วงคริสต์มาส
|
|
|
|
|
บันทึกการเข้า
|
|
|
|
เทาชมพู
เจ้าเรือน
หนุมาน
    
ตอบ: 41829
ดูแลเรือนไทย วิชาการ.คอม
|
|
ความคิดเห็นที่ 65 เมื่อ 18 ธ.ค. 19, 16:31
|
|
คิดถึงคุณป้าซูซาน บอยล์มาก เธอหายไปเลยในปีหลังๆนี้ มีข่าว(ซึ่งไม่รู้ว่าเชื่อได้ไหม)ว่าดวงดาวของเธอดับวูบไปแล้ว จากแรงกดดันของการเป็นบุคคลสาธารณะ ยังรักเสียงเธออยู่มาก จึงนำเพลงเดียวกับข้างบนนี้มาให้ฟังค่ะ เธอร้องประสานเสียงกับจอห์นนี่ แม็ทธิส จากคนละฟากสมุทร
|
|
|
|
|
บันทึกการเข้า
|
|
|
|
|
SILA
|
|
ความคิดเห็นที่ 66 เมื่อ 19 ธ.ค. 19, 14:07
|
|
Less is More More is ...
|
 คลิกที่รูปเพื่อขยาย/ย่อ
|
|
|
บันทึกการเข้า
|
|
|
|
|
SILA
|
|
ความคิดเห็นที่ 67 เมื่อ 19 ธ.ค. 19, 14:09
|
|
เข้ามาดู ต้นคริสต์มาสในบ้าน ที่แปลกแตกต่างเก๋ไก๋กู๊ดไอเดีย
ต้นคริสต์มาสยุคหน้า
|
|
|
|
บันทึกการเข้า
|
|
|
|
|
SILA
|
|
ความคิดเห็นที่ 68 เมื่อ 19 ธ.ค. 19, 14:10
|
|
ต้นคริสต์มาสของ บรรณารักษ์
|
|
|
|
บันทึกการเข้า
|
|
|
|
|
SILA
|
|
ความคิดเห็นที่ 69 เมื่อ 19 ธ.ค. 19, 14:11
|
|
ของ นักจัดวาง, จับตั้ง
|
|
|
|
บันทึกการเข้า
|
|
|
|
|
SILA
|
|
ความคิดเห็นที่ 70 เมื่อ 19 ธ.ค. 19, 14:12
|
|
ของ นักเคมี
|
|
|
|
บันทึกการเข้า
|
|
|
|
|
SILA
|
|
ความคิดเห็นที่ 71 เมื่อ 19 ธ.ค. 19, 14:13
|
|
นักจุลชีววิทยา
|
คลิกที่รูปเพื่อขยาย/ย่อ
|
|
|
บันทึกการเข้า
|
|
|
|
|
SILA
|
|
ความคิดเห็นที่ 72 เมื่อ 19 ธ.ค. 19, 14:17
|
|
นักอนุรักษ์ธรรมชาติ ประดิษฐ์จากขวดพลาสติคใช้แล้ว
|
|
|
|
บันทึกการเข้า
|
|
|
|
|
SILA
|
|
ความคิดเห็นที่ 73 เมื่อ 19 ธ.ค. 19, 14:21
|
|
ต้นคริสต์มาสจิ๋วห้อยย้อยใยแมงมุมโดยคุณแม่
|
|
|
|
บันทึกการเข้า
|
|
|
|
|
SILA
|
|
ความคิดเห็นที่ 74 เมื่อ 19 ธ.ค. 19, 14:25
|
|
และ ที่ สนามบิน Vilnius, Lithuania - ต้นคริสต์มาสประดิษฐ์จากสิ่งของที่ยึดจากผู้โดยสาร เช่น มีด กรรไกร ไฟแช็ค ปืนปลอม ส่วนดาวบนยอดนั้นประกอบจากมีดตัดเนย
|
|
|
|
บันทึกการเข้า
|
|
|
|
|